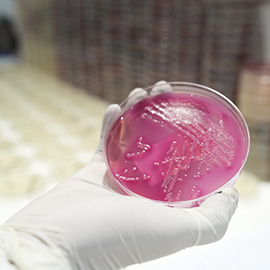
Micro

Chughtai Lab
Discount Cards
Health Profiles
Free Home Sampling Services
Home sample collection has become a popular choice among patients due to several benefits. However, it is crucial to choose the right lab to ensure accurate diagnosis. Here are some of the major reasons that make Chughtai Lab a trusted option including;
Collection Center / Locations
We are committed to providing top-quality diagnostic services and medical tests across all major cities in Pakistan. With our extensive network of state-of-the-art laboratories, collection centers, and the convenience of home sample collection, accessing reliable healthcare services has never been easier.
For more information and booking
Locate your nearest Chughtai Lab collection center for fast, reliable, and convenient diagnostic services.
Our Regional Labs
Bringing Quality Diagnostics Closer to You
Chughtai Lab operates regional laboratories in the following cities across Pakistan:
- Karachi
- Rawalpindi
- Bahawalpur
- Multan
- Gujrat
- Faisalabad
- Gujranwala
- Peshawar
- Sargodha
- Sahiwal
- Lahore
- Quetta
- Abbottabad
- Rahim Yar Khan
Chughtai Blood Bank
Blood Bank is a vital component of patient care, operating on the principle of commitment to safety, precision, and efficiency. The department is staffed round-the-clock by a dedicated team of consultant hematologists, skilled medical technologists and trainee residents ensuring seamless support for both routine and emergency transfusion needs.
We work in close coordination with clinical teams to provide timely and compatible blood products, adhering to stringent quality and safety protocols. Patient and physician concerns are handled with the utmost attention, and our medical staff takes the time to offer expert guidance on transfusion-related
queries.
To guarantee the safety and integrity of every unit of blood, we utilize state of the art testing technology. High-end equipment allows us to perform precise blood group matching, including extended antigen typing when required and delivers a safe NAT tested blood to those in need.
Our Blood Bank offers a comprehensive range of services, including:
- Whole Blood and Component Preparation (Packed Red Cells, Platelets, Plasma, Cryoprecipitate)
- ABO and Rh Typing
- Crossmatching
- Red blood cell phenotyping
- Antibody Screening and Identification
- Direct and Indirect Coombs Test
- NAAT (Nucleic Acid Amplification Testing) for HIV, HBV, and HCV
- Syphilis and Malaria Screening
- Apheresis Services (Plateletpheresis)
- Blood Inventory Management

Blood Bank Locations:
- Head Office: 7-Jail Road, Gulberg II, Lahore
- 49 G Block, DHA Phase 1, Lahore
- Plot No. 2, Block 3, P.E.C.H.S, Shaheed-e-Millat Road, Karachi
- Chughtai Medical Center, Sialkot Road Gujranwala
- Chughtai Lab Sahiwal
In addition to blood bank services Transfusion services are also provided ensuring the safe and appropriate use of blood and blood components. It also ensures hemovigilance and transfusion reaction reporting, in line with the best practices to promote patient safety and continual quality improvement.
The department also plays a strong academic and research role. We actively engage in research and innovation, with multiple papers published in peer reviewed journals and participation in national and international academic forums.
Our Blood Bank stands as a model of excellence for combining clinical expertise, cutting-edge technology, and a deep commitment to education, safety, and patient centered care.
Departments
Cutting-Edge Diagnostics with Specialized Technical Expertise
Each department is led by highly qualified specialists and equipped with advanced diagnostic technology, ensuring the highest standards of quality and patient care. From disease detection and prevention to personalized treatment insights, our expert teams employ internationally recognized protocols and cutting-edge methodologies to enhance healthcare outcomes.
Whether it’s histopathology for cancer diagnosis, molecular genetics for inherited disorders, or microbiology for infectious diseases, our comprehensive approach ensures that every test result is backed by expertise, accuracy, and trust. With a relentless focus on quality assurance, continuous research, and technological advancement, Chughtai Healthcare remains at the forefront of modern diagnostic medicine, shaping the future of healthcare in Pakistan.
Chughtai Lab App
The Chughtai Lab Application is an excellent tool for accessing all your lab reports on the go. It also provides the convenience of finding nearby Chughtai Lab locations.
With the App, you can effortlessly create and manage your profile, giving you access to your complete history of lab reports, including details of our other services. Download the App now and enjoy the convenience and efficiency it offers.
- Available on iOS and Android